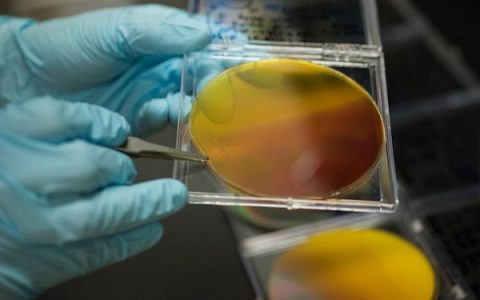
新的材料制作工艺将加速太阳能商业化进程

材料牛注:美国能源部艾米斯实验室(Ames)的科学家们首次制备出一种纯单晶铁基超导材料,这种材料的性质与现有超导理论模型所预测的结果相矛盾。 艾米斯实验室(Am...

材料牛注:还在抱怨化石燃料的种种弊端?告诉你个好消息,研究人员已经帮你解决这一问题了:新的材料制作工艺将可实现太阳能的生产并加速其商业化进程。 科学家们发现了一...

材料牛注:3D打印给我们带来了太多惊喜,新型3D-CMF表面打印技术的鬼斧神工或将进一步开启家用3D打印的新纪元。 上图所示分别为印刷表面平滑前(1)、常规方法...

材料牛注:石墨烯,由于其独特的物化性质而成为二维层状材料领域的引领者。然而,最近德国慕尼黑工业大学(TUM)的研究人员开发出了一种新型聚合物包覆硅纳米片复合材料...



材料牛注:低维纳米材料往往有独特的功能。近日,哈佛大学的研究团队发表了轻质纳米纤维的最新设计和制作方法。所制备出的这种纳米纤维重量轻,可被纺丝并制成效果极好的防...







材料牛注:厉害了,仿生3D打印技术!近来,华盛顿州立大学利用仿生3D打印技术复制出了强硬轻质结构,下面就让我们揭开仿生3D打印技术神秘面纱,一探究竟。 诸如木材...



材料牛注:可以在电网上存储间歇性的太阳能和风能,闪电般的超级电容器(锂离子电池的三倍),可以在极冷和炎热的环境中良好工作(-20°C~60°C),解决了电池的火...

材料牛注:作为第一种既是金属又是半导体的材料,改变了我们看待光传输的方式,解决了光子学中信号损失的问题、同时提高光传输的效率?这就是集气质与实力于一身的新型等离...
